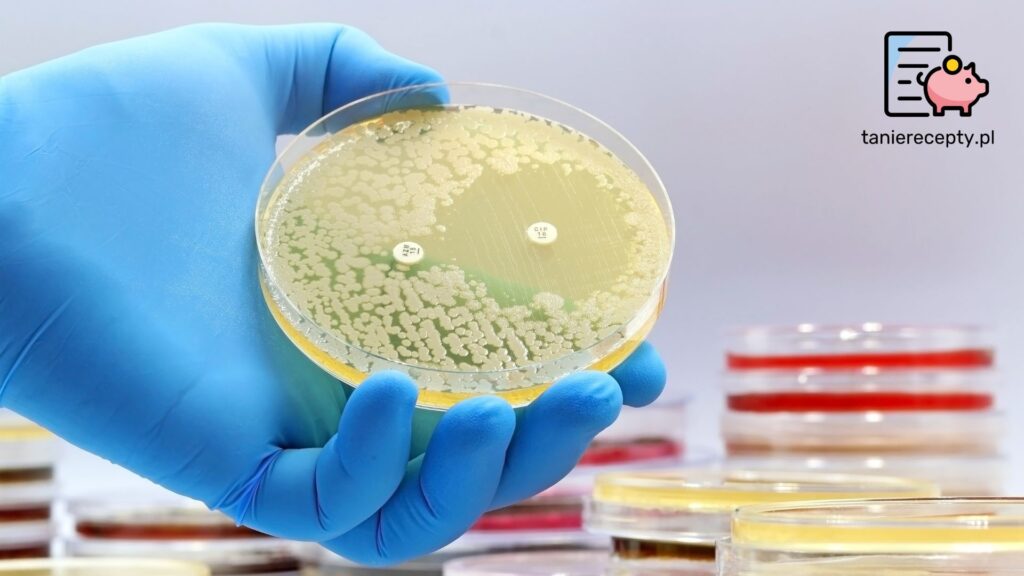

Zanieczyszczenie wody stanowi jedno z najpoważniejszych zagrożeń dla zdrowia publicznego na całym świecie. Skażona woda może przenosić groźne patogeny i wywoływać choroby układu pokarmowego, takie jak biegunka, zapalenie wątroby typu A czy infekcje pasożytnicze. W szczególności powodzie i brak dostępu do czystej wody potęgują tego typu zagrożenia. W artykule omówimy, jak je rozpoznawać, jakie są ich skutki, oraz jak skutecznie uzdatniać wodę w sytuacjach kryzysowych.
Powódź — jaki ma wpływ na jakość wody?
Powodzie są jednym z głównych czynników zanieczyszczających wodę, a ich wpływ na zdrowie publiczne jest ogromny. Kiedy dochodzi do zalania terenów zamieszkanych, woda pitna często zostaje skażona odpadami, ściekami i chemikaliami. To stwarza dogodne warunki do rozwoju i przenoszenia patogenów, w szczególności bakterii kałowych takich jak bakterie z rodzaju Salmonella czy Escherichia coli, ale również wirusy, grzyby patogenne, chorobotwórcze pierwotniaki, a także pasożyty. W wyniku powodzi dochodzi do zaburzeń w funkcjonowaniu infrastruktury sanitarno-higienicznej, co potęguje ryzyko wystąpienia epidemii chorób zakaźnych. Brak dostępu do czystej wody oraz trudności w zapewnieniu odpowiedniej higieny w okresie popowodziowym zwiększają ryzyko wystąpienia chorób takich jak cholera czy leptospiroza. Aby ograniczyć to ryzyko, kluczowe jest szybkie przywrócenie dostaw bezpiecznej wody pitnej oraz edukacja mieszkańców w zakresie podstawowych zasad higieny.
Skutki spożycia zanieczyszczonej wody na układ pokarmowy
Spożycie zanieczyszczonej wody może prowadzić do szeregu poważnych problemów zdrowotnych związanych z układem pokarmowym. Najczęstszym skutkiem jest ostra biegunka, która może powodować szybkie odwodnienie organizmu, zwłaszcza u małych dzieci i osób starszych. Odwodnienie to może prowadzić do zaburzeń elektrolitowych, co z kolei osłabia funkcjonowanie nerek i serca. W przypadku ciężkich zakażeń może dojść do sepsy, która jest stanem zagrożenia życia. Innym skutkiem spożycia skażonej wody jest narażenie na zakażenie wirusem zapalenia wątroby typu A, które może powodować długotrwałe uszkodzenie tego organu, prowadząc do żółtaczki i osłabienia funkcji wątroby. Osoby zakażone mogą doświadczać nudności, wymiotów, bólu brzucha oraz ogólnego osłabienia. Aby radzić sobie z zakażeniami spowodowanymi zanieczyszczeniem patogenami wody pitnej, kluczowe jest natychmiastowe leczenie, które obejmuje nawadnianie doustne lub dożylne w przypadku znacznego odwodnienia oraz odpowiednią terapię przeciwwirusową, lub antybiotykową w zależności od rodzaju zakażenia. Profilaktyka, w tym dostęp do bezpiecznej wody, odgrywa najważniejszą rolę w zapobieganiu tego typu problemom zdrowotnym.
Jak rozpoznać Salmonellozę?
Salmonelloza to choroba zakaźna wywołana przez pałeczki Salmonella, bakterie przenoszone głównie przez skażoną żywność i wodę. Objawy salmonellozy obejmują biegunkę, gorączkę, ból brzucha i nudności, które pojawiają się zwykle w ciągu 6-72 godzin po spożyciu zakażonego pokarmu. Zakażenia są zazwyczaj łagodne, jednak u osób starszych, małych dzieci i osób z osłabionym układem odpornościowym mogą prowadzić do poważnych komplikacji.
Jak przebiega czerwonka bakteryjna?
Czerwonka bakteryjna, znana także jako szigeloza, to poważna choroba zakaźna wywołana przez bakterie z rodzaju Shigella. Przebieg choroby jest zwykle gwałtowny i zaczyna się od gorączki, która może sięgać 38-40°C. Gorączka często towarzyszy intensywnym bólom brzucha, skurczom jelit oraz biegunkom, które mogą występować nawet kilkanaście razy dziennie. W stolcu mogą pojawić się krew, śluz i ropa, co jest charakterystycznym objawem ciężkiej postaci choroby. Inne objawy to nudności, wymioty, ogólne osłabienie, bóle głowy, a u niektórych pacjentów dochodzi do odwodnienia z powodu utraty dużej ilości płynów.
Zakażenie Campylobacter
Kampylobakterioza to choroba zakaźna wywołana przez pałeczki Campylobacter, które przenoszą się głównie przez spożycie skażonej żywności, zwłaszcza surowego lub niedogotowanego drobiu, niepasteryzowanego mleka oraz skażonej wody. Zakażenie najczęściej objawia się gorączką, bólami brzucha, biegunką (często z domieszką krwi), a także nudnościami i wymiotami. Charakterystycznym elementem kampylobakteriozy są silne bóle brzucha, które często przypominają te występujące przy zapaleniu wyrostka robaczkowego, co może prowadzić do błędnej diagnozy.
Jak uzdatnić wodę podczas kryzysu?
Podczas sytuacji kryzysowych, takich jak powodzie, gdy dostęp do czystej wody jest ograniczony, konieczne staje się uzdatnienie wody, aby uniknąć chorób zakaźnych. Jednym z pierwszych kroków jest ocena czy w wodzie znajdują się widoczne „gołym okiem” cząstki, takie jak piasek, muł czy inne większe osady. Takich zanieczyszczeń można pozbyć się przez filtrowanie. Natomiast niewidoczne gołym okiem czynniki patogenne, takie jak bakterie, wirusy, pasożytnicze pierwotniaki czy pasożyty można zniwelować poprzez zastosowanie wysokiej temperatury lub środków chemicznych. Przegotowanie wody przez co najmniej jedną minutę (utrzymanie wrzenia przez 1 minutę), to najskuteczniejszy i najprostszy sposób zabijania większości patogenów, w tym bakterii, wirusów i pasożytów. Jeśli jest możliwość dłuższego gotowania wody — jest to zalecane. Inne metody obejmują stosowanie środków chemicznych, takich jak tabletki lub krople z chlorem (w postaci np. podchlorynu sodu) lub jodem. Przed użyciem chemicznych środków dezynfekcyjnych, warto wodę przefiltrować, aby usunąć większe zanieczyszczenia. W sytuacji, gdy woda jest silnie zanieczyszczona, można użyć przenośnych filtrów z węglem aktywnym, które dodatkowo poprawiają smak i zapach wody. Jednak najbezpieczniejszym rozwiązaniem, jeśli to możliwe, jest spożywanie w takich momentach wody butelkowanej, która jest sprawdzona i gotowa do spożycia bez konieczności uzdatniania. Warto także unikać wody z nieznanych źródeł, zwłaszcza w miejscach dotkniętych klęskami żywiołowymi.